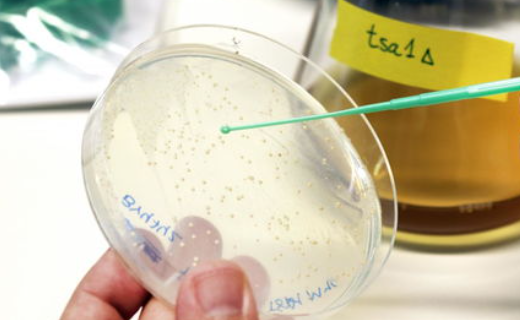

申请危化品企业生产许可证的注意事项有哪些?
危化品经营许可证办理需要注意什么?
同时,在办理危险货物经营许可证后,还要办理危险货物经营许可证,尤其是办理危险货物经营许可证后要注意的问题,由于国家对危险化学品的管理很严格,有关部门也会不定时地检查,在申请危化品许可证后,要注意的问题很多,在办理完这几件事之后,小编今天就想把这些事情和大家分享一下。有几个问题在许可证申请完成后仍需注意,否者有可能被吊销危化证,下面我们上海将简单列出几个问题,但愿对企业家有所帮助,如果你需要进一步了解,可向我所的专业顾问咨询,他们会给你详细的讲解。有关规定:已取得经营许可证的企业变更企业名称、主要负责人、注册地址或危险化学品储存设施及其监控措施的,应当在变更之日起20个工作日内,向发证机关提出书面变更申请,并提供下列文件:对未按规定办理变更手续的企业,责令限期改正,处1万元以下的罚款;逾期未申请变更的,处1万元以上3万元以下的罚款。二是危险化学品经营企业存在主要负责人和安全管理人员相互插手等问题。执法人员在接受换证或检查过程中,发现有一些企业主要负责人同时兼任安全管理人员,或者是这家危化品企业的安全管理人员,也可能是这家危化品企业的安全管理人员。危化品经营属于高风险行业,上海危险化学品仓库主要负责人和安全管理人员必须持有证书。它对于相关人员的能力素质和工作内容有着不同的要求。而企业的主要负责人和安全管理者,都是各自负责,不能互相代替。三、危险化学品超限经营是一种许可行为,危化品的经营类型和经营方式均须经发证机关批准,不得擅自扩大经营品种范围,还不能擅自改变经许可核准的经营方式,如检查发现,办理危险化学品生产许可证的,可以按无证经营的危险化学品立案处罚。上述情形,若情节较重,又有撤销危化证的可能,故在完成危化证处理后,还要严格准守有关规定。
如何办理危化品许可证?基本条件有什么?
对于危化证很多化工企业比较清楚,而一些刚进入这一行的创业者们,可能就比较陌生了。根据国家的相关规定,凡是要经营危险品的办企业,都要按照相关规定申请危化证,不然那就会被当作无证经营。那危化证应该怎么办理呢?需满足的基本条件有哪些?为您讲解。一、办理危化证要满足的基本条件如下:
1、企业经营危化品的场地,相关设施与建筑物等,都要符合《建筑设计防火规范》、《爆炸(危险场所安全规定》等规定。此外,建筑物还要获得消防验收机构的合格。
2、企业的经营条件和储存条件等,要满足《常用危险化学品储存通则》等规定。
3、公司的主要负责人,安全生产管理人员等要经过专业培训,并且通过所有的考核,获得上岗资格。
4、拥有健全的安全生产管理制度,符合国家标准的应急救援预案等。
5、提供安全评价报告,需要是有资质的第三方提供。
6、相关部门要求的其他重要条件。
二、办理危化证可以采用的方法:
1、现在办理危化证的方式并不多,常见的有2种,一种是企业自己准备资料办理,另外一种是请专业的代办公司申请。
2、这两种方式的选择,需要根据企业的实际情况来讲,毕竟每家公司的情况不同。
3、不过,从总体上看,大部分的企业还是会选择专业的代办公司,因为他们的专业的团队,办事效率高,服务态度好。更加熟悉相关的政策和流程,通过率会更高。
申请危化证的相关讲解,讲到这里就结束了,这里需要提醒大家,办理危化证要先弄清楚政策,不能盲目的办理,也不能跟风办理,不然吃亏的还是自己。
危化品许可证办理
法律分析:危险化学品经营许可证的颁发管理工作实行企业申请、两级发证、属地监管的原则。国家安全生产监督管理总局指导、监督全国经营许可证的颁发和管理工作。省、自治区、直辖市人民政府安全生产监督管理部门指导、监督本行政区域内经营许可证的颁发和管理工作。
法律依据:《危险化学品经营许可证管理办法》
第四条 经营许可证的颁发管理工作实行企业申请、两级发证、属地监管的原则。
第五条 国家安全生产监督管理总局指导、监督全国经营许可证的颁发和管理工作。
省、自治区、直辖市人民政府安全生产监督管理部门指导、监督本行政区域内经营许可证的颁发和管理工作。
设区的市级人民政府安全生产监督管理部门(以下简称市级发证机关)负责下列企业的经营许可证审批、颁发:
(一)经营剧毒化学品的企业;
(二)经营易制爆危险化学品的企业;
(三)经营汽油加油站的企业;
(四)专门从事危险化学品仓储经营的企业;
(五)从事危险化学品经营活动的中央企业所属省级、设区的市级公司(分公司)。
(六)带有储存设施经营除剧毒化学品、易制爆危险化学品以外的其他危险化学品的企业;
县级人民政府安全生产监督管理部门(以下简称县级发证机关)负责本行政区域内本条第三款规定以外企业的经营许可证审批、颁发;没有设立县级发证机关的,其经营许可证由市级发证机关审批、颁发。
审核中
危化品经营许可证办理条件
1、经营和储存场所、设施、建筑物符合国家标准规定,建筑物应当经公安消防机构验收合格。
2、经营条件、储存条件符合《危险化学品经营企业开业条件和技术要求》、《常用危险化学品储存通则》的规定。
3、单位主要负责人和主管人员、安全生产管理人员业务人员必须经过专业培训考核合格。
4、有健全的经营管理制度和安全生产管理制度。
5、有本单位事故应急救援预案。
注意事项:
第一类:爆炸品,是指在外界作用下(如受热、摩擦、撞击等)能发生剧烈的化学反应,瞬间产生大量的气体和热量,使周围的压力急剧上升,发生爆炸,对周围环境、设备、人员造成破坏和伤害的物品。

第二类:压缩气体和液化气体,指压缩的、液化的或加压溶解的气体。

第三类:易燃液体,本类物质在常温下易挥发,其蒸气与空气混合能形成爆炸性混合物。

第四类:易燃固体、自燃物品和遇湿易燃物品,这类物品易于引起火灾。

第五类:氧化剂和有机过氧化物,这类物品具有强氧化性,易引起燃烧、爆炸。